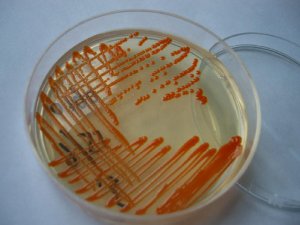

试题中心
各地 动态 |
全国 | 北京 | 天津 | 上海 | 重庆 | 河北 | 山西 | 贵州 | 黑龙江 | 辽宁 | 吉林 | 江苏 | 浙江 | 安徽 | 福建 | 江西 |
| 河南 | 山东 | 湖南 | 湖北 | 广东 | 海南 | 四川 | 云南 | 内蒙古 | 广西 | 陕西 | 甘肃 | 宁夏 | 青海 | 西藏 | 新疆 |
 临床医学检验图 变性巨核细胞
日期:2012-03-31 13:19:37
点击:193
好评:0
临床医学检验图 变性巨核细胞
日期:2012-03-31 13:19:37
点击:193
好评:0
变性巨核细胞:胞浆有空泡或玻璃样变性,颗粒少甚至无颗粒;核染色质松散、网状或呈粗条索状,核可分叶甚至分叶较多。以上二者可单独存在,亦可两者皆有。多见于ITP。...
 临床医学检验图 放线菌
日期:2012-02-16 15:31:06
点击:170
好评:2
临床医学检验图 放线菌
日期:2012-02-16 15:31:06
点击:170
好评:2
临床医学检验图 放线菌 放线菌(图)...
 临床医学检验图 单增李斯特氏菌
日期:2012-02-16 15:30:42
点击:170
好评:0
临床医学检验图 单增李斯特氏菌
日期:2012-02-16 15:30:42
点击:170
好评:0
临床医学检验图 单增李斯特氏菌 单增李斯特氏菌...
 临床医学检验图 大肠杆菌(图2)
日期:2012-02-16 15:30:15
点击:318
好评:0
临床医学检验图 大肠杆菌(图2)
日期:2012-02-16 15:30:15
点击:318
好评:0
临床医学检验图 大肠杆菌(图2) 大肠杆菌(图2)...
 临床医学检验图 大肠杆菌(图1)
日期:2012-02-16 15:29:46
点击:118
好评:0
临床医学检验图 大肠杆菌(图1)
日期:2012-02-16 15:29:46
点击:118
好评:0
临床医学检验图 大肠杆菌(图1) 大肠杆菌(图)...
临床医学检验图 粘质沙雷菌菌落形态
日期:2012-02-16 15:29:16
点击:172
好评:-2
临床医学检验图 粘质沙雷菌菌落形态
日期:2012-02-16 15:29:16
点击:172
好评:-2
临床医学检验图 粘质沙雷菌菌落形态 粘质沙雷菌菌落形态...
 临床医学检验图 腐败希瓦菌在MAC上形态
日期:2012-02-16 15:28:46
点击:236
好评:0
临床医学检验图 腐败希瓦菌在MAC上形态
日期:2012-02-16 15:28:46
点击:236
好评:0
临床医学检验图 腐败希瓦菌在MAC上形态 腐败希瓦菌在MAC上形态...
 临床医学检验图 腐败希瓦菌在BAC上形态
日期:2012-02-16 15:27:50
点击:197
好评:0
临床医学检验图 腐败希瓦菌在BAC上形态
日期:2012-02-16 15:27:50
点击:197
好评:0
临床医学检验图 腐败希瓦菌在BAC上形态 腐败希瓦菌在BAC上形态...
 临床医学检验图 细胞质微粒残余
日期:2011-10-21 16:40:21
点击:182
好评:2
临床医学检验图 细胞质微粒残余
日期:2011-10-21 16:40:21
点击:182
好评:2
细胞质微粒残余...
 临床医学检验图 滚动着的细胞
日期:2011-10-21 16:39:50
点击:151
好评:0
临床医学检验图 滚动着的细胞
日期:2011-10-21 16:39:50
点击:151
好评:0
滚动着的细胞...